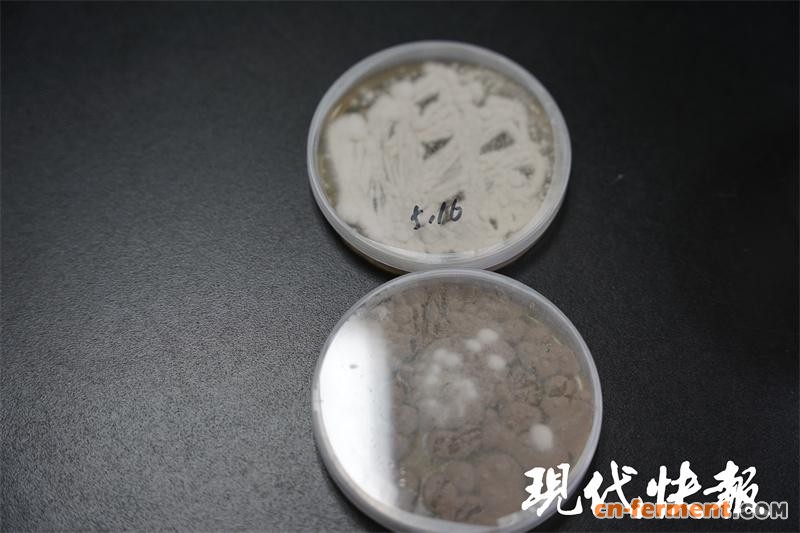

意外的发现,温室里的小白虫全死光
" 如同人类会生病一样,农作物也会‘生病’。农作物会受到病原物、害虫的侵扰,我们的团队主要从事农业害虫生物防治方面的研究。" 近日,现代快报记者来到江苏省农业科学院植物保护研究所,见到了该研究所副所长、害虫生物防治创新团队首席郭慧芳。

△ 江苏省农业科学院植物保护研究所副所长郭慧芳
郭慧芳和农业结缘已有 24 年,她常年与田地里的害虫打交道,她的愿望很朴素:为农民破解病虫害难题,让消费者吃上放心的绿色食品。
搞科研,需要具备一双慧眼。郭慧芳不仅自己和害虫 " 斗 " 了二十余载,还经常向团队里的同事和学生灌输这样的理念:" 若在大自然中发现了死虫子,要把它们当宝贝,千万别当作看不到。" 研究所的微信群里,科研人员们时常就某一种害虫展开激烈讨论。

△ 被爪哇虫草菌杀死的害虫 农科院供图
郭慧芳带领的团队共有 5 名成员,还有部分研究生。" 郭老师,我们温室里面的虫子全死掉了,白白一片。"2011 年梅雨时节的某一天,团队里的一名研究生跑来向郭慧芳汇报。这种 " 小白虫 " 名叫烟粉虱,是一种世界性的超级害虫。烟粉虱刺吸植物汁液直接造成植物伤害,更重要的是能传播破坏性极强的植物病毒病,是联合国粮农组织认定的世界第二大害虫。
普通人看到这一堆虫子可能惊慌失措,而他们却高兴坏了。" 赶紧把这些死虫子采集回来,进行分离鉴定。"
分离出杀虫真菌,是冬虫夏草的 " 亲戚 "
在研究所的养虫室,现代快报记者见到了烟粉虱。它依附在叶片上,体形很小,通体纯白色,长着一对半透明的小翅膀。

△ 叶子上的烟粉虱
番茄、黄瓜、西葫芦 …… 超过 600 余种植物都是它的盘中餐,甚至连花卉都逃不过它的 " 魔掌 ",每年造成全球数十亿美元的经济损失。
有害虫就喷农药,提及农药,很多人会把它跟毒药挂钩。化学农药虽然能有效控制害虫,但缺点也不容忽视,如杀伤天敌和有益微生物,甚至造成人畜中毒、环境污染等。
△ 爪哇虫草菌培养皿
不能用化学农药,那如何防治害虫呢?团队另辟蹊径,想到了用真菌。" 真菌作为天然杀虫剂,不会在农产品上留下危险残留物,也不会对使用它的人构成危险。" 团队从田间发病烟粉虱分离获得一种高效低风险的广谱杀虫真菌——爪哇虫草菌 JS001。

△ 爪哇虫草菌 JS001
现代快报记者了解到,该真菌和冬虫夏草同门同属,它们之间有 " 亲戚关系 "。
高效易用成本低,准确 " 猎杀 " 目标害虫
当前,绿色农业已成为农业发展主旋律,利用生物资源开发的农药逐渐崭露头角。
分离鉴定,活性研究,规模发酵 …… 在郭慧芳的带领下,团队历经十余年的潜心研发,最终实现了爪哇虫草菌 JS001 母药及制剂的正式登记。这也开创了由科研单位创制并登记新农药正式获批进入农业生产应用领域的先河。

△ 使用新型农药后,植物生长情况较好,叶片分叉较多
" 番茄烟粉虱每年危害上千万亩次以上,传播的病毒病年发生几百万亩以上;稻飞虱每年危害均在上亿亩次以上。" 郭慧芳介绍,爪哇虫草菌产品除能杀死番茄上的烟粉虱外,还能防治水稻、花卉上的飞虱、蚜虫、叶螨等害虫,在植物病毒病的防控上也表现出较好的效果。另外,使用成本不高,一亩地只需要二十元左右就可以了。
郭慧芳拿出产品展示给现代快报记者," 可分散油悬剂是最适合的剂型,用水稀释 1500 倍,在任何虫态均可施药,于傍晚均匀喷雾于叶正反面,使用方便,田间持效一个月以上。"
大面积推广应用,助力绿色农业发展
防治效果这么好,市场推广如何呢?
郭慧芳介绍,2013 年以来,产品先后示范应用在江苏、广东、山东、安徽等地区,有效控制住蔬菜、水稻、花卉上的烟粉虱、稻飞虱、蚜虫等重大害虫的发生,并进行了大面积推广示范。
" 当时我们还未取得农药登记证,为示范区农民免费发放使用时,他们都问这个药在哪里能买到。" 郭慧芳回忆," 农户们说,看到我们就像看到了亲戚一样,他们还会把自己种植的蔬菜送给我们,让我们特别感动。"
对于农民生产的事,郭慧芳都很上心,她认为这是她的职责所在。郭慧芳告诉现代快报记者,他们有意向转让科技创新成果,通过科企合作,发挥产品的使用价值,助力农业绿色高效生产。
" 目前团队获批了两项相关国家自然科学基金面上项目,进一步深入的基础研究将为科学开发和应用新农药产品带来更大的突破。" 郭慧芳表示,未来,团队将继续推动基础研究和应用研究的融合,针对农业生产中的重大虫害问题,研发更多高效低毒的生物源农药,为农业绿色发展贡献力量。













